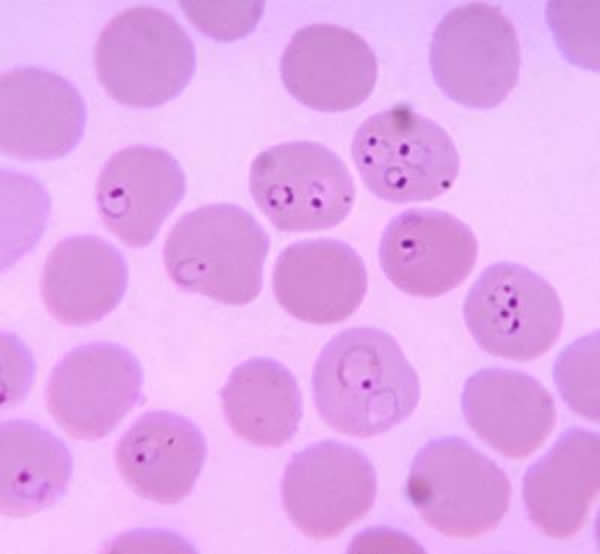

疟原虫环状体

9.间日疟:环状体(红)和大滋养体(蓝)
图片尺寸640x479
有一种难过叫,我不在这里 ——君安精选案例"散点话疟疾"_疟原虫
图片尺寸1080x720
疟原虫疟疾环状状态
图片尺寸1200x800
这幅图片展示了红细胞,其中一些被环状体阶段的疟原虫感染.
图片尺寸600x554
人红细胞中处于环状期的恶性疟原虫.
图片尺寸640x426
寄生虫画图⑥ (间日疟原虫环状体,间日疟大滋养体,间日疟未成熟裂
图片尺寸1708x1280
单环双核,双环双核(瑞士-吉姆萨染色)多个较小疟原虫环状体寄生同一红
图片尺寸1117x726
有一种难过叫,我不在这里 ——君安精选案例"散点话疟疾"_疟原虫
图片尺寸1080x720
恶性疟原虫
图片尺寸1200x800
血细胞分析仪测定和读片分析疟原虫感染
图片尺寸474x368
疟原虫切片(环状体和滋养体)_哔哩哔哩 (゜-゜)つロ 干杯~-bilibili
图片尺寸1086x610
疟原虫具有抗药性 e.
图片尺寸281x696
图片讨论顾剑飞老师:在涂片镜检时,发现有白细胞吞噬裂殖体的现象
图片尺寸1080x504
恶性疟原虫的介绍
图片尺寸1337x747
疟原虫|抗疟药|抗药性_网易订阅
图片尺寸582x776
这种薄膜显微照片描绘了环形式间日疟原虫感染rbc; 1 rbc包含两个环.
图片尺寸452x300
人体寄生虫学实验实验7间日疟原虫
图片尺寸1080x810
恶性疟原虫环状体记了但什么都没记上的实验记录
图片尺寸1762x2048
nejm间日疟原虫案例报道
图片尺寸291x292
看图识细胞第48期疟原虫专场
图片尺寸750x563